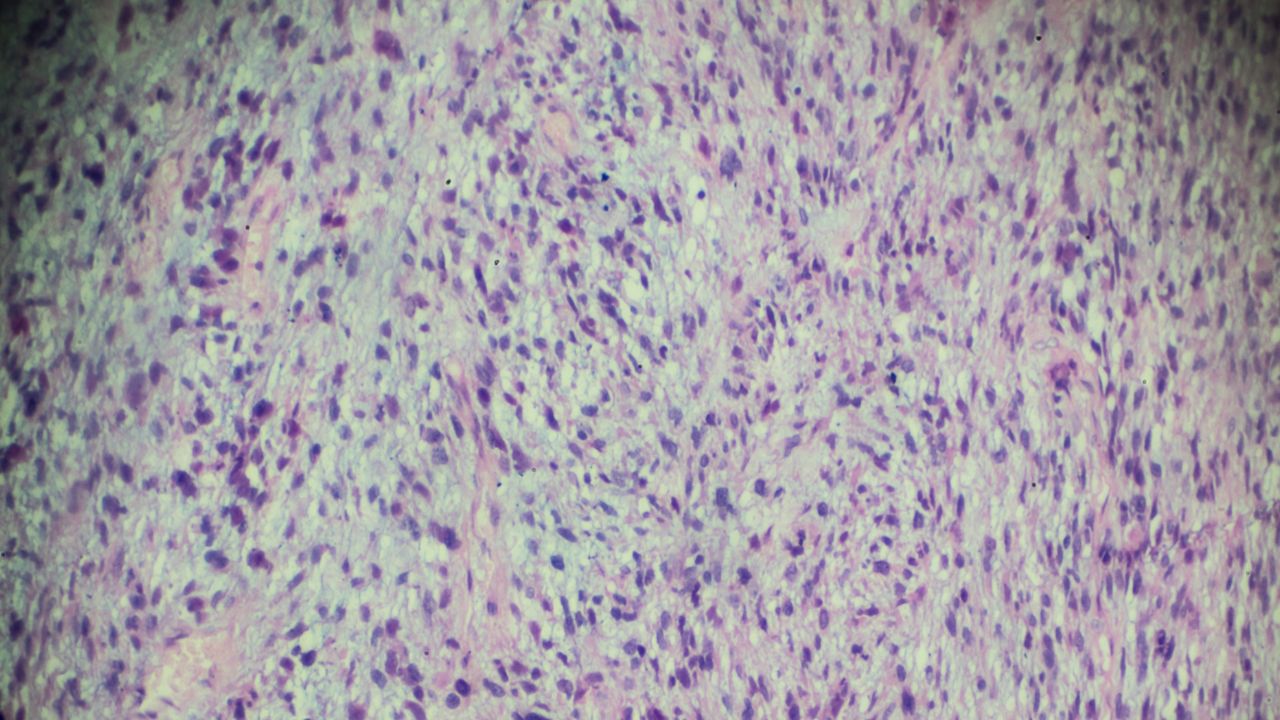
جراحی تومور استخوانی جراحی تومور استخوانی

رابدومیوسارکوم (Rhabdomyosarcoma) یکی از چالشبرانگیزترین تومورهای بدخیم در حوزه انکولوژی کودکان و نوجوانان است. این بیماری که از سلولهای تمایزنیافته ناشی میشود، نیازمند رویکردی دقیق و تیمی برای مدیریت و درمان است.
رابدومیوسارکوم چیست؟
رابدومیوسارکوم نوعی سرطان تهاجمی و نادر از دسته سارکوم بافت نرم است. این بیماری در سلولهای مزانشیمی که قرار است به ماهیچههای اسکلتی (ارادی) تبدیل شوند، ایجاد میشود. این سلولهای پیشساز عضلانی، در اصطلاح پزشکی رابدومیوبلاست نامیده میشوند.
نکته حائز اهمیت این است که اگرچه ماهیچههای اسکلتی عمدتاً در دستها و پاها قرار دارند، اما رابدومیوسارکوم میتواند در هر نقطهای از بدن ظاهر شود؛ حتی در مناطقی که در حالت عادی فاقد عضله اسکلتی هستند، مانند گوش میانی، مثانه یا مجاری صفراوی.
علائم و نشانههای سرطان رابدومیوسارکوم
علائم رابدومیوسارکوم بسیار متغیر است و کاملاً به محل تومور، اندازه آن و میزان تهاجم به بافتهای مجاور بستگی دارد. در ادامه برخی از نشانههای آن را آوردهایم.
- شایعترین نشانه، لمس یک توده یا مشاهده تورمی است که بهمرور بزرگتر و دردناک میشود.
- در صورت درگیری ناحیه سر و گردن، بیمار ممکن است دچار بیرونزدگی چشم (پروپتوز)، افتادگی پلک، دوبینی، سردردهای مداوم، خونریزی مکرر از بینی، گلو یا گوش و احتقان مزمن سینوسی شود.
- علائمی نظیر وجود خون در ادرار (هماچوری)، دشواری در دفع ادرار یا اجابت مزاج رایج است.
- توده سفت و بهسرعت در حال رشد که در صورت فشار بر رشتههای عصبی، منجر به درد، بیحسی یا حس گزگز در اندام مربوطه میشود.
- درگیریهای شکمی میتواند با درد مبهم، استفراغ یا یبوست مزمن تظاهر یابد.
علت بروز رابدومیوسارکوم چیست؟
علت دقیق و ریشهای بروز رابدومیوسارکوم هنوز بهطور کامل کشف نشده است.
تحقیقات فعلی نشان میدهند که تومور زمانی رشد میکند که در DNA سلولهای بافت نرم تغییرات و جهشهایی ایجاد شود، یعنی منشا ژنتیکی دارد.
عوامل خطر ابتلا به تومور رابدومیوسارکوم
عوامل خطر مواردی هستند که احتمال ابتلای فرد به بیماری را بالا میبرند، اما لزوماً به معنای ابتلای قطعی نیستند:
- سن: بیشترین شیوع آن در کودکان زیر ۱۰ سال است.
- سندرمهای ژنتیکی ارثی: برخی شرایط ژنتیکی خانوادگی خطر ابتلا را بهشدت افزایش میدهند. سندرمهای ژنتیکی ارثی مرتبط با افزایش خطر رابدومیوسارکوم شامل سندرم لیفرومنی، نوروفیبروماتوز نوع یک، سندرم بکویت ویدمن، سندرم نونان، سندرم کاستلو و سندرم دایسر یک هستند.
- عوامل پیش از تولد: برخی مطالعات به ارتباط احتمالی بین وزن بالای نوزاد هنگام تولد و افزایش خطر این سرطان سارکوم اشاره کردهاند. همچنین، مصرف مواد مخدر مانند ماریجوانا یا کوکائین توسط والدین پیش از تولد نوزاد، بهعنوان یک عامل خطر احتمالی تحت مطالعه است.
تشخیص سرطان رابدومیوسارکوم
تشخیص رابدومیوسارکوم بهصورت مرحلهای انجام میشود و از معاینه بالینی آغاز و با بررسیهای تخصصی تکمیل میشود.
در این مسیر، تصویربرداری پیشرفته نقش مهمی دارد. MRI برای ارزیابی دقیق بافت نرم، سی تی اسکن برای بررسی ریهها و در صورت نیاز پت اسکن یا اسکن استخوان برای تشخیص متاستاز و میزان گسترش بیماری استفاده میشود.
تشخیص قطعی تنها با بیوپسی امکانپذیر است. در این مرحله، نمونهای از بافت تومور از طریق سوزن یا جراحی برداشته میشود تا بررسی شود. نمونه برداشتشده تحت آنالیز پاتولوژی و ایمونوهیستوشیمی قرار میگیرد و وجود مارکرهای اختصاصی عضلانی مانند میوژنین و دسمین بررسی میشوند.
در برخی موارد، برای تمایز دقیق بین انواع مختلف رابدومیوسارکوم، آزمایشهای مولکولی و ژنتیکی انجام میشود. همچنین در صورت شک به گسترش بیماری، آسپیراسیون و بیوپسی مغز استخوان لازم است.
جهت تشخیص و درمان دیسک کمر نزد دکتر صادق صابری، با شمارههای زیر تماس بگیرید:
مجتمع پزشکی صدر: ۰۲۱۷۹۱۸۴۰۰۰
مرکز تخصصی تهران ارتوپدی: ۰۲۱۹۱۳۰۴۵۰۴
روشهای درمان رابدومیوسارکوم
درمان تومور رابدومیوسارکوم یک کار گروهی است که شامل درمانهای زیر است:
1. جراحی
نخستین قدم، برداشتن کامل تومور با حاشیه سالم است. در برخی موارد، بهویژه اگر تومور به استخوان مجاور گسترش یافته باشد، جراحی تومور استخوان نیز انجام میشود تا توده بهطور کامل حذف شود و عملکرد عضو حفظ شود.
بهدلیل نزدیکی تومور به ارگانهای حساس (مانند چشم یا مثانه)، همیشه جراحی وسیع امکانپذیر یا توصیهشده نیست.
2. شیمیدرمانی
برخلاف بسیاری از سرطانها، در رابدومیوسارکوم تقریباً تمام بیماران به شیمی درمانی نیاز دارند. زیرا این تومور مستعد پخششدن در مقیاس میکروسکوپی است.
3. پرتودرمانی (رادیوتراپی)
برای از بین بردن باقیمانده تومور پس از جراحی یا کنترل تومورهایی که قابل جراحی نیستند، از اشعههای پرانرژی استفاده میشود. امروزه استفاده پروتون تراپی بهدلیل عوارض جانبی کمتر در کودکان، مورد توجه قرار گرفته است.
4. رویکردهای آینده و کارآزماییهای بالینی
در موارد عودکننده یا مقاوم به درمان، از روشهای زیر استفاده میشود:
- ایمونوتراپی: تحریک سیستم ایمنی برای شناسایی سلول سرطانی.
- درمان هدفمند: داروهایی که مستقیماً به جهشهای ژنتیکی سلول حمله میکنند.
- پیوند سلولهای بنیادی: برای حمایت از بدن پس از دوزهای بسیار بالای شیمیدرمانی
شانس بهبودی به محل تومور، نوع بافتشناسی و میزان گسترش آن بستگی دارد. با تشخیص بهموقع و درمانهای چندگانه مدرن، نرخ بقا در بسیاری از کودکان مبتلا به فرمهای موضعی بهطرز چشمگیری افزایش یافته است.

0 Comments